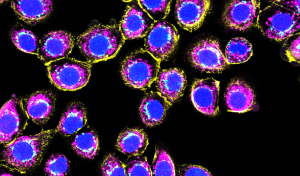
Bronchial-Epithelial-Cells_DAPI_Golgin97_MITO_Phal_60x_1

A recent study published in 2018 showed that laundry detergent and detergent residue left behind after rinsing may be responsible for the increase in asthma and allergy in humans. Synthetic laundry detergents contain numerous ingredients that are irritants and sensitizers. Surfactants, the substance responsible for creating suds in the wash and bleaches can irritate the skin and respiratory airways leading to the lungs, while fragrances and enzymes can induce sensitization. Researchers found that anionic surfactants disrupt the lining of the airways (bronchial mucosal epithelial barrier) leading to the lungs.
Laundry Detergents
Laundry detergents are primarily made of synthetic surfactants which are responsible for cleaning clothes by solubizing and lifting grease and grime. Laundry detergents also contain other ingredients such as bleaches, enzymes, and fragrances. Surfactants and bleaches can cause irritation to the skin and lungs, while enzymes and fragrances can act as sensitizers, inducing allergic immune responses leading to asthma and other allergic diseases such as atopic dermatitis.
Hypersensitivity
Sensitization causes changes to the immune system resulting in hypersensitivity to the substance that caused it, in which exposure to even minute amounts of that substance results in a greater allergic response than is normal.
Hypersensitivity is also known as a Type 2 allergic reaction in which it may take several minutes or several hours for a response to develop. In this type of allergic response antibodies to the offending substance interact with antigens (receptors) on the cell surface leading to cell lysis (type of cell death).
Surfactants
Surfactants are surface-active agents and comprise a group of chemicals that are known primarily for their cleansing ability, but also have antimicrobial properties (surfactants can kill bacteria, fungi, and protozoa. Unlike soaps which are made from natural ingredients (plant oils or animal fats), surfactants are synthetic (man-made) and have a chemical structure comprising a water-soluble polar head and a hydrophobic (doesn’t solubilize in water) nonpolar tail.

History of Use and Environmental Impact
Environmental contamination with surfactants result in ecological damage to rivers and lakes, and result in toxicity to algae, fish, and can also negatively impact bacteria (such as nitrogen-fixing bacteria needed for decomposition of organic matter). While surfactants are greatly removed from waste-water at water-treatment plants, a small amount remains in sewage water and the portion that is removed during water-treatment accumulates in sludge. Sewage water and sludge are released into the aquatic environment where surfactants can then spread and contaminate water, soil, and sediment.
There are several classes of surfactants: anionic, cationic, nonionic, and amphotheric. Laundry detergents are generally anionic or cationic. Anionic detergents are the oldest most common surfactants and contain sulfate, sulphonate, or phosphate. Phosphates are responsible for causing algal growth in rivers and lakes, and in a book written by William McGucken in 1995, it was exposed that detergent companies knew of the toxic effect of phosphates since the 1950’s, but denied any such knowledge to the public while looking for safer alternatives. Cationic detergents do not contain phosphates, but are quaternary ammonium compounds. They are mostly used in detergents and fabric softeners, and a can also be found in hair conditioners.
How Landry Detergent Causes Allergic Disease
The airway is lined with cells called epithelial cells. Airway epithelial cells form a surface barrier against inhaled environmental insults from microbes, allergens, and toxicants. A defect in this barrier is associated with asthma. Anionic surfactants were found to directly disrupt the barrier integrity by breaking lipid-lipid interactions and lipid-protein interaction. Additionally, genes associated with cell adhesion and collagen synthesis were down regulated (suppressed) while genes for lipid metabolism were significantly upregulated (promoted). As a result, the protective mucous membrane breaks down becomes less viscous and cells membranes become permeable to insult. Impaired barrier integrity can increase the penetration of harmful substance causing an inflammatory response and increase the possibility of sensitization from repeated exposure.
Less is More
While detergents are made to be more versatile than ordinary soap ( work in a wide range of temperatures and hard-water, and rinses cleaner) they have added toxicities, because they are formulated with multiple ingredients synthetic surfactants, bleaches, fragrances, enzymes that are irritants. Fragrances from detergents and fumes from bleaches can be inhaled and cause respiratory problems, while residues from using too much soap or over-loading laundry machines leaves residue on clothing resulting in contact dermatitis. Repeated exposure to all may result in the development of allergies. Those with asthma are even more susceptible. There are many mild laundry detergents on the market today that are free of dyes and fragrances, and produce less suds allowing for a cleaner rinse. If you suffer from respiratory disease, are prone to allergies, or have sensitive skin it may be necessary to pay attention to how you launder you clothes in the future.
Reference
2. Tomislav Ivankovic and Jasna Hrenovic. 2010. Surfactants in the Environment. Archives of Industrial Hygiene and Toxicology Volume 61:1 p 95-110.